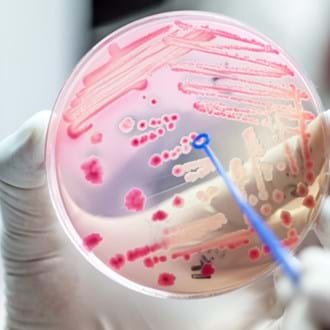

Clean water and sanitation
In focus: Clean water and sanitation
The following selected resources support SDG 6 knowledge and will equip you with up-to-date sustainability related information and tools.
Please note: Some of these links will take you to an external source. Whilst these have been reviewed by our Technical Advisory Group, they do not necessarily represent the opinions and views of IChemE.

Victoria (Australia) Water Company GHG Emissions Summary - Proud Mary Consulting
SEPTEMBER 2025 This document presents and inventory of Victoria's greenhouse gas emissions and tracks emissions since a baseline in 2015. The breakdown is a total and by water company. The document also discusses recent trends in carbon reduction.

Wastewater Treatment Plant Optimisation and Emissions Profiles - AM Team
SEPTEMBER 2025 (Opens YouTube) Dive into a real-world case with Evides Industriewater and discover how a smart blend of monitoring and modelling helped cut emissions, optimize processes, and meet regulatory demands. This is a must-watch for any utility tackling climate goals with limited resources.

Understanding Gasification for PFAS Removal | The Water Research Foundation
SEPTEMBER 2025 PFAS is a key contaminate of concern in wastewater treatment. This fate of PFAS in wastewater treatment appears to be largely in the solids phase and ultimately in the biosolids. Biosolids reuse is an important sustainability driver to avoid these biosolids being sent to landfill. Land spreading or compost are traditional end use options at the moment, however PFAS creates high risk with these pathways. Gasification and pyrolysis are now being seen as opportunities to create a safe circular economy with biosolids. This research discusses the information available on the fate of PFAS in these processes.

Carbon Capture and Green Hydrogen in Denmark
SEPTEMBER 2025 Denmark has some of the most stringent requirements and advanced targets in the world for assessing and mitigating process emissions. They are in the process of piloting a new technology to evaluate Carbon Capture and production of Green Hydrogen. This article outlines the technology and the project aims.

State of Water Sector in the UK in Resource Recovery
SEPTEMBER 2025 This report discusses the place of resource recovery in the UK as it currently stands. This also has a link to other information and summarises other studies from GWI etc.

PFAS Risk Policy Position - CIWEM
SEPTEMBER 2025 CIWEM believes more robust policies are required to reduce public health and environmental risks from PFAS (per- and polyfluoroalkyl substances). They engaged experts from across the water and environment sectors and developed a way forward for strengthening policies on PFAS, set out in a new Policy Position Statement. The document also introduces the key issues surrounding PFAS, and acts as a useful ‘crash course’ to the subject.

Methane Emissions from Anaerobic Digestion - UK
SEPTEMBER 2025 This report published by the UK Government outlines the results of research into fugitive methane emissions from anaerobic digestion sites, including an assessment of different measurement techniques. It is becoming widely understood that methane leakage / fugutive emissions are common place in anaerobic digesters and needs to be understood to properly evaluate GHG emissions inventories and develop process trains for solids streams and circular economy.

SWRF 2024 Climate Change - YouTube
SEPTEMBER 2025 This video outlines the Water Research Foundation's overview of risk evaluation and responses to climate change. This provides a high level introduction into the material available from the Water Research Foundation who undertake research and provides toolkits for water utilities and the water sector.

Resource recovery from wastewater in the USA
APRIL 2022 This article links to an initiative from the US Department of Energy (DOE) aiming to accelerate resource recovery from municipal wastewater across the USA. The outcomes include a fascinating range of technologies.

National Bioresources Strategy - UK
MAY 2025 UKWIR has published research on the recovery of resources from wastewater, with recommendations to focus on readily available opportunities. UKWIR shortlisted existing opportunities such as reuse of final effluent water, processing biosolids and maximisation of uses for other outputs including grit, ash and heat. It concluded also that high priority should go to resources where the technology to extract them was mature and implementable, but where regulation and market preparation were incomplete. Of note is the discussion on the emerging uses of pyrolyis, gasification and incineration where we are particularly concerned on contaminants of concern (with a strong focus on PFAS).

PPPs bringing sustainable finance to international development
MAY 2025 The following publication outlines research undertaken to evaluate Public Private Partnerships in international development. This aligns success across different geographies and sectors with a direct connection to the Sustainable Development Goals. This follows on from the interesting interview with Dr Euan Low on SDG 6 - see Success Stories. (https://www.icheme.org/knowledge-networks/blog/sustainability-success-story-dr-euan-low)

US based net zero targets in the water sector
MAY 2025 This article highlights the developing movement for advanced water companies across the world to move towards net zero. Many water companies around the world are taking active steps without an active push from governments. This approach must be highlighted and applauded as we move towards a more sustainable future.

Process Emissions Database from IWA Congress
FEBRUARY 2025 A must for anyone working on and trying to understand process emissions – this database is the most up to date information on process emissions currently available. There are a number of masterclasses and webinars/webcasts as well as publications. There are links to active groups that are leading research and implementation of process emissions monitoring, modelling and mitigation.

Europe's state of water 2024: the need for improved water resilience
FEBRUARY 2025 The following report outlines the findings of the study on Europe’s state of water for 2024 by the European Environment Agency. The report outlines three key challenges within the need for improved water resilience. These are: 1. protecting and restoring aquatic ecosystems; 2. achieving the zero pollution ambition; 3. adapting to water scarcity, drought and flood risks. This is a great source of knowledge and relevant for all outside of Europe as all jurisdictions are exposed to the effects of climate change.

UKWIR – GHG Emissions Phase 1 Report
SEPTEMBER 2024 The objective of this project was to start the practical journey for the UK and Irish water industry in the understanding of their process emission of nitrous oxide (N2O) and fugitive emissions of methane (CH4) from wastewater treatment plants. The research project has reviewed global and UK based monitoring campaigns, highlighted methodological requirements and knowledge gaps and provided a design of a national monitoring programme. This is the phase 1 report.

UKWIR – GHG Emissions Phase 2 Report
SEPTEMBER 2024 The objective of this project was to start the practical journey for the UK and Irish water industry in the understanding of their process emission of nitrous oxide (N2O) and fugitive emissions of methane (CH4) from wastewater treatment plants. The research project has reviewed global and UK based monitoring campaigns, highlighted methodological requirements and knowledge gaps and provided a design of a national monitoring programme. This is the phase 2 report.

UKWIR – Whole of life carbon reduction
SEPTEMBER 2024 This report focuses on whole of life carbon reduction. This report aligns to PAS2080 and the UK Infrastructure Carbon Review.

UKWIR – GHG Emissions – Optimisation of existing processes
AUGUST 2024 The first phase of UKWIR’s research on process emissions from WWTWs suggested that they are currently underestimated, particularly in relation to nitrous oxide (N2O). Phase two tested this through UK-based monitoring, and the accumulating evidence is that process emissions are likely the largest part of water sector operational emissions. This publication focuses on the practical opportunities to reduce, control, and mitigate nitrous oxide and methane emissions at wastewater treatment works.

UKWIR – GHG Emissions Nature Based Solutions
AUGUST 2024 UKWIR provides a number of research papers. These are relevant across the water industry and include information on a range of relevant topics and new research. This publication highlights greenhouse gas emissions from nature based solutions such as wetlands, ponds / lagoons etc. It should be noted that this publication is largely based on a literature review.

Final PFAS National Primary Drinking Water Regulation
AUGUST 2024 This ground breaking policy is the first of its kind to develop limits for the various PFAS et al compounds. This presentation provides background as to the development of the limits and a set of limits. The document also includes implementation and monitoring recommendations.

Water Environment Federation
MAY 2024 The Water Environment Federation (WEF) is a key source of information for water professionals. WEF is a not for profit organisation focusing on technical and educational information sharing amongst over 30,000 members and 75 affiliated member associations. This is a great source for the latest technical information across the water sector, including a key focus on sustainability and human health issues.

Low carbon concrete
MAY 2024 Laing O'Rourke are global leaders in developing sustainable construction methods. This article provides an overview of their development of low carbon technologies, much of this has been developed for the water industry in the UK, for projects such as the Daveyhulme WWTW upgrade where a large portion of the concrete was pre-fabricated and put together on site. This is a high level overview for people interested in innovative sustainable construction methods.

US Water Alliance climate change articles
MAY 2024 The US Water Alliance is a US National Water membership organisation. The Alliance publishes articles on all aspects of water and has a focus area on climate change. This provides articles on activities across the US including research, funding and policy.

GHG emissions monitoring in USA
MAY 2024 US Water Alliance has provided grant funding and selected partners to complete and document the research works. This is an exciting step in the US as it aligns with other countries in quantifying and mitigating Greenhouse Gas Emissions from its wastewater treatment plants.

Net zero ideas in water – Podcast by Antoine Walter
MARCH 2024 This podcast outlines a set of ideas in the water sector to achieve net zero. The podcast starts with an outline of emissions in the water sector when compared to other sectors. This provides different examples across the water sector, water networks to wastewater treatment and provides tangible examples of efficiencies in terms of both cost savings and achieving net zero ambitions.

Maria Manidaki interview - Podcast by Antoine Walter
MARCH 2024 This interview with Maria Manidaki outlines examples around the world where best practice in the water sector is being achieved. Maria was an author of the Infrastructure carbon review, PAS 2080 and the UK Water Road to Net Zero and is a global thought leaders around reducing carbon across all parts of water infrastructure development. She highlights the need for leadership, future education and integration and more innovative procurement.

Singapore Green Plan
NOVEMBER 2023 The Singapore government is one of the most progressive governments in the world in adopting sustainable practices. This is a whole of nation plan to advance sustainable practices across Singapore.

Global Change Data Lab
DECEMBER 2023 This site provides an excellent tracker of the SDG 6 goals. The tracker provides graphical summaries by region and by country in an easy to follow display. This is a great resource for tracking performance and financial flows by area.

Open source knowledge hub for water sustainability
DECEMBER 2023 This site presents an outline of water savings technologies and a number of excellent links to relevant publications. This is a valuable resource for all members working in water savings programs.

Water stewardship and indigenous water inclusion
NOVEMBER 2023 Water Stewardship Asia Pacific is a not for profit organisation that has a mission is to protect and enhance the natural environment through water stewardship to achieve our vision of a water-secure world for all. Several prominent organisations began to form an international panel of experts responsible for developing a new standard for water stewardship. The website provides training links, the framework developed through the panel of experts and a set of articles and publications as well as news and is a useful source of information for people seeing to improve water management.

Quantification and modelling of fugitive greenhouse gas emissions from urban water systems
SEPTEMBER 2022 IWA have released a novel publication focusing on emissions from wastewater networks and treatment plants for both nitrous oxide and methane emissions. The publication outlines the challenges associated with emissions as part of global net zero targets. The various models for quantification of emissions are tested against the latest research for both networks and treatment systems. There are case studies on measurement, quantification and mitigation measures developed around the world for you to explore.

Quantifying, modelling and mitigating process emissions masterclasses
JUNE 2023 This material provides a series of master classes presenting the release of the International Water Association manual for the quantification and modelling of fugitive greenhouse gas emissions from Urban Water systems. This is important as it provides an overview including questions from the wider industry on findings as part of the development of the publication.

How can we solve water scarcity?
JUNE 2023 The droughts in Europe over the 2022 summer have put extra pressures on the food supply chain, this article from New Food reviews the problem and what we can do working in the industry to use water efficiently as we move towards summer 2023. The article provides the link of food systems and water and outlines sustainable agricultural innovation outlining a systems approach to reducing water scarcity.
Tackling AMR in wastewater in a carbon neutral way
JUNE 2022 Anti-microbial resistance continues to be a major threat to the human race, with millions now dying from previously treatable illnesses. This webinar dives into AMR’s presence in wastewater, receiving water and how we can tackle this issue in a carbon friendly way.

Quantification and modelling of fugitive GHG emissions from urban water systems
JUNE 2022 The water sector and in particularly wastewater transfer and treatment are contributors to GHG emissions across the world. As increased pressure is felt in the water sector to transition to a low-carbon model, this digital publication focusses specifically on reducing nitrous oxide and methane emissions which occur mostly from the transfer and treatment of wastewater.

Safe drinking water & sanitation
JUNE 2023 This link from the Institute for Water Education provides an outline on current water scarcity numbers around the world, latest research, a set of courses available to provide further learning and a number of articles written through Delft. This provides discussion of technical, social, economic and institutional aspects associated with the provision of safe drinking water and sanitation. There is also a link to the Citywide Inclusive Sanitation (CWIS) approach developed through Delft. This provides a number of examples where this approach is used and also a link to key partnerships around the world.

Desalination in the EU
APRIL 2022 Desalination plants have been built to respond climate change and augment freshwater supply. This article link provides an overview and breakdown categories of varying aspects in desalination in Europe, particularly southern Europe. This report is part of climate-resilient Europe.

In focus: Clean water and sanitation archive
For more information and tools, visit the archive.